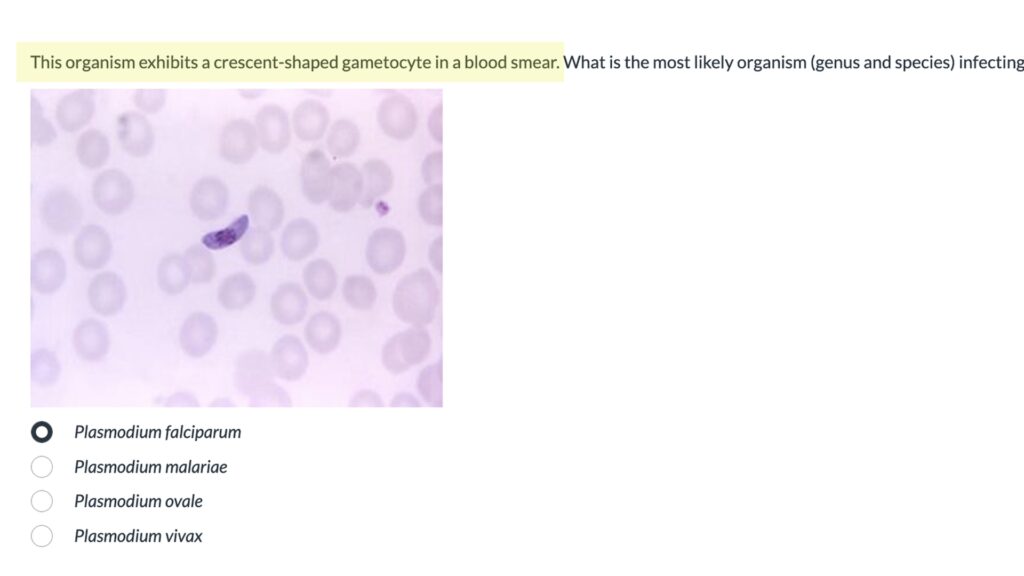
An example of an assessment with a question about the image of a crescent-shaped gametocyte in a blood smear.

Last updated on December 19, 2025
Parasitology is a dense and highly visual subject matter that can be challenging for students to navigate. Students are asked to differentiate between organisms that often share similar traits, while also learning how those organisms infect hosts and affect their bodies.
In the redesigned MLAB 409: Parasitology – developed in partnership with Professor Karen Myers, Director of the Colorado Center for Medical Laboratory Science – students are guided through this complexity with a course design that emphasizes clarity, structure, and diagnostic thinking. Through a carefully organized sequence of lessons, visual resources, and practice opportunities, the course supports students as they progress from foundation understanding to real-world application.
Contents
Video Spotlight
[Length 5:11, CC Available]
Strategic Course Structure
MLAB 409 is organized around a consistent module structure that mirrors educational psychologist Robert Gagné’s 9 Events of Instruction, a learning theory that emphasizes designing courses to match the natural flow of how our brains learn new information.
Each module begins with an overview page that gains the learner’s attention, establishes learning objectives, and stimulates recall of prior learning (the first three of Gagné’s 9 Events). For the module lessons (the fourth event), each module focuses on one or two groups of parasites – amoebae, tapeworms, etc. Within each module, students begin with a lecture video that introduces the organism group at a high level, focusing on shared characteristics and key concepts. Then, they move into instructor-created reading pages that examine individual organism species in greater detail. These pages follow a uniform internal structure, covering things like morphological traits, modes of infection, and the effects on the host’s body. This consistency makes the content both easier to navigate and easier to digest.

Each module’s lessons are followed by summary pages that highlight the most important diagnostic features for each organism. These pages cover the fifth learning event, “provide guidance,” and also serve as useful study aids and quick-reference resources for open-note assessments.

Practice, Feedback, and Diagnostic Thinking
Practice opportunities are also directly built into each module. Students engage with ungraded practice activities that allow them to check their understanding and receive immediate feedback (events 6 and 7) before moving into assessments. These activities encourage students to actively apply what they’ve learned and identify areas where they may need additional review.

Each module concludes with a short assessment (event 8) aligned with the learning objectives, with summative assessments at the course midpoint and endpoint. After completing the online modules, students transition into a hands-on laboratory workshop, where they apply their learning in authentic diagnostic contexts (event 9: transfer learning to real-word application).
Thoughtful Media Design
According to Cognitive Load Theory, it’s important to break content into digestible chunks, so we worked extensively with Karen to keep all lecture videos around 15 minutes or less. We also helped her keep these videos focused on key traits and common features, leaving the heavy lifting of species-level detail to the reading pages. Additionally, we followed the 5x5x5 rule of slide design to ensure no individual slide was overloaded with information, which could compromise retention.

Accessible Visual Content
Per Colorado state law, our courses are required to uphold certain accessibility standards, including providing text descriptions that capture the instructional value of any images that appear in the course content.

Parasitology, as a discipline, is visually intensive, as diagnosing infections often requires visual identification of parasites in patient samples. Therefore, this course contains hundreds of images, and every last one of them needed a text description. And when it comes to images in assessment questions, we had to carefully craft descriptions that provide the learner with all the necessary details to answer the question, without giving away the answer outright. How do you describe a nematode egg without coming right out and calling it a nematode egg? It can be tricky, but we got it done by combining Karen’s domain expertise with our instructional design expertise.
Of course, the importance of accessibility goes way beyond mere regulatory compliance. And as we always say: accessibility is for everyone, not just our students with impairments. The text descriptions are available to all students as a tool to interpret and understand the copious visual content throughout the course.
Conclusion
This project is a great example of the power of strong fundamentals in course design. The revamped MLAB 409: Parasitology course is far more scaffolded, more uniform, more digestible, more accessible, and above all, more learning theory-driven.
Partnering for Continuous Improvement in Teaching and Learning
A significant factor in the success of this and similar projects is the support and funding from the Office of Online Learning (OOL), which has been instrumental in enhancing the quality of our online educational endeavors. OOL’s support and contributions have empowered faculty members to innovate and create a more enriching educational environment for all. Please visit the Office of Online Learning for more information about all that they are doing to help MSU Denver faculty members and students.
Want to get involved?
One way to find help with implementing student supports in your course is the CTLD Course Development Cycle. This is an intensive, but rewarding, process where an instructional designer will work with you over the course of several months to identify course objectives, develop learning activities, create a user-friendly course, record high-quality multimedia content, and much more.
For more information on the CTLD Development Cycle, as well as how to apply to join, please see our CTLD Course Development Cycle spotlight.
Have questions?
Want help on this or other teaching and learning topics? Please visit us for drop-in support (10am-3pm, M-F) or try one of our self-help tutorials.